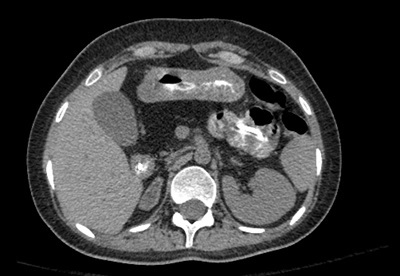

Opitz G/BBB Syndrome

- Occular hypertelorism.
- Defects of the larynx, trachera and oesophagus. Laryngeal cleft.
- Hypospadius, crypto-orchidism, bifid scrotum.
- Mild intellectual disability, ASD.
- Cleft lip/palate.
- Imperfoate anus,
- absent corpus callosum.
- Prominent forehead, widows peak hair line, flat nasal bridge, thin upper lip,
- low set ears.

CHARGE Syndrome
- Coanal artresia
- Heart (TOF, PDA, VSD, ASD, Right aortic arch)
- Atresia Choanae
- Retarded growth (CNS abnormalities)
- Genitourinary/hypogonadism
- Ears
DiGeorge Syndrome
- CATCH22
- Microdeletion on Chromosome 22
- Cardiac
- ‘Abnormal face’ low set east, wide set eyes
- Thymic hypoplasia
- Cleft palate
- Hypocalcaemia: absence or underdevelopment parathyroid
22q11.2 deletion syndrome
Dr Francis Deng◉ and Dr Gagandeep Singh et al.
22q11.2 deletion syndrome, also known as the DiGeorge syndrome or velocardiofacial syndrome, is a syndrome where a small portion of the chromosome 22 is lost and results in a variable but a recognisable pattern of physical and behavioral features.
Epidemiology
The estimated incidence is at ~ 1 in 4000-6000 live pregnancies 4,10.
Clinical presentation
CATCH 22 is the mnemonic to remember the chromosome and all the abnormalities.
cleft lip +/- palate
congenital heart disease (particularly conotruncal anomalies): often a major part of this syndrome
tetralogy of Fallot
interrupted aortic arch
truncus arteriosus
characteristic facies
elongated face
short philtrum
facial asymmetry
prominent nose
hypernasal speech
learning disabilities
decreased immunity
malformation of third and fourth pharyngeal pouches that result in the defective development of the parathyroid and thymus which can, in turn, lead to
hypoparathyroidism
hypocalcemia
Pathology
Genetics
There is a near-universal association with a deletion within chromosome 22q11.2. The majority of cases have de novo mutations. 22q11 deletions are associated with some types of conotruncal cardiac defects as well as conotruncal anomaly face syndrome 5.
Associations
Mondini malformation
choanal atresia
Radiographic features
Temporal bone malformations are common: 7:
lateral semicircular canal dysplasia with small or absent bony island, forming a wide or single cavity with the vestibule (42% and 26%, respectively)
cochlear incomplete partition type II (32%)
middle ear ossicles
dense stapes superstructure (39%)
malleus, incus, or other stapes abnormalities (7%)
carotid canal dehiscence (10%)
Brain and cerebrovascular malformations are common 6,8:
persistent cavum septi pellucidi and/or cavum vergae (19-33%)
aberrant cortical veins (25%)
polymicrogyria or cortical dysplasia (17%)
white matter hyperintensities (10%)
hypoplastic internal carotid artery (8%)
brain volume loss, most pronounced in the cerebellum (see hypoplastic cerebellum) 9
Cardovascular, particularly conotruncal, defects are usually the first imaging abnormality noted in these patients 10:
cardiac anomalies
tetralogy of Fallot and variants (35%)
interrupted aortic arch (type B) (19%)
truncus arteriosus (9%)
ventricular septal defect (16%)
atrial septal defect (2%)
transposition of the great arteries (2%)
vascular anomalies
right aortic arch (35%)
vascular ring (5%)
aberrant origin of subclavian artery (16%)
mirror image brachiocephalic vessel branching (12%)
left superior vena cava (9%)
History and etymology
First described in 1968 by Angelo DiGeorge (1921-2009), an American physician.
https://radiopaedia.org/articles/22q112-deletion-syndrome-1
Apert Syndrome

- AKA Type 1 acrocephalosyndactyly
- The constellation of findings is consistent with Apert syndrome (type I acrocephalosyndactyly). Apert syndrome is an autosomal dominant genetic disorder caused by a mutation in the FGFR2 gene encoding the fibroblast growth factor receptor, which is involved in signaling immature fibroblasts into bone cells. It is characterized by craniosynostosis (premature fusion of calvarial sutures) and syndactyly. Additional imaging features include midface anomalies (including shallow orbits and choanal stenosis), cervical spine fusion (seen in 71% of cases and most commonly involving the fifth and sixth vertebrae), skull-base hypoplasia, and central nervous system (CNS) anomalies (including gyral abnormalities, hypoplastic white matter, callosal agenesis, enlarged ventricles, and heterotopic gray matter).

A 12-year-old patient presents with hyperglycemia, neutropenia, and bone dysplasia.
Shwachman-Diamond disease is the second most common reason behind fatty atrophy of the pancreas in children, the first reason being cystic fibrosis. The disorder is characterized by pancreatic exocrine insufficiency, fatty atrophy of the pancreas, neutropenia, and bone dysplasia.
Von Hippel-Lindau Disease
- Characterised by the development of numerous benight and malignant tumours in different organs
- Due to mutation in the VHL tumour suppressor gene on chromosome 3.
- 1:35000-50000
- Usual dx iwhti ntheir first tumour in early adult hood (mean age 26)
- Abdominopelvic
- renal
- RCC, usually clear cell type and frequently bilateral
- 70% life time risk
- RCCs present at an earlier age (mean 39 years) in pt with VHL
- Renal cysts
- can occur in 75% of patients
- Often tned to be bilateral and multiple
- Can be simple, complex or cystic RCC
- Renal angiomyolipomas
- Adrenal
- Phaeo (25-30% of patients)
- Extra- adrenal phaeochromocytoma/paraganglioma (15%)
- Pancres
- Pancreatic cysts (40%)
- pNET (12.5%)
- Usually non-functional
- frequently multiple
- Pancreatic serous cystadenoma
- pancreatic adenocearcinoma
- Liver
- cysts
- Urogenital
- epididymal cysts
- Papillary cystademon of the epididymis (35%)
- broad ligament cystadenomas
- CNS
- Haemangioblastomas: occure in 70% patients
- Cerebellar
- Spinal cord
- brainstem
- Choroid plexus papilloma
- Haemangioblastomas: occure in 70% patients
- H&N
- Rentinal haem
- Adrenal
- renal
13 yo male with short Stature and webbed neck
Noonan syndrome
Noonan syndrome
Assoc Prof Frank Gaillard◉◈ and Dr Yuranga Weerakkody◉ et al.
Noonan syndrome (NS) is a genetically and phenotypically heterogeneous non-aneuploidic congenital RASopathy. Affected individuals can bear some clinical features similar to that of Turner syndrome.
Epidemiology
The estimated incidence is at ~1 in 1000-2500 10. As individuals have normal number of chromosomes, both males and females can be affected.
Clinical presentation
An immense number of clinical features have been described which can be present at varying degrees. These include:
craniofacial
telecanthus, hypertelorism
low-set ears, rotated ears +/- thickened helix
epicanthus
facial asymmetry
intellectual disability
microgenia
low neck hairline
cervicothoracic
pterigium colli: webbed neck
winged scapulae
pectus excavatum
pectus carinatum
cardiopulmonary
pulmonary stenosis (with dysplastic pulmonary valve): most common cardiac anomaly 3
hypertrophic cardiomyopathy 3,4: thought to affect ~20% of individuals 3
patent ductus arteriosus (PDA)
vascularcongenital lymphovascular abnormalities
cystic hygroma
lymphedema 5
lymphangiectasia(e) 2
generalized musculoskeletal
short stature
hypotonia
delayed sternal ossification 7
renal anomalies
dilated renal pelvices 6,9
Pathology
Genetics
The inheritance is autosomal dominant although a significant proportion of cases are sporadic 8. Many genes have been implicated, the most common being the PTPN11 gene which encodes for SHP2, which results in an inability to inactivate SHP2 causing increased signaling of the Ras/MAPK pathway. However. other genes that may be less commonly implicated including SOS1, KRAS, RAF1, NRAS, and SHOC2 10. Because of its effect in amplifying the Ras/MAPK pathway, it is considered to be a RASopathy 10.
Radiographic features
Antenatal ultrasound
Early 1st trimester ultrasound may show nuchal edema or a cystic hygroma similar to that of Turner syndrome. With subsequent scanning, some of the above individual clinical features may be present sonographically.
History and etymology
It is named after Jacqueline A Noonan (1928-fl 2019), an American pediatric cardiologist 11.
Turners Syndrome
Effects both males and females
T or F
false
Turner syndrome
Dr Joachim Feger◉ and Assoc Prof Frank Gaillard◉◈ et al.
Turner syndrome, also known as 45XO or 45X, is the most common of the sex chromosome abnormalities in females.
Epidemiology
The incidence is estimated at 1:2000-5000 of live births, although the in utero rate is much higher (1-2% of conceptions) due to a significant proportion of fetuses with 45X aborting by the 2nd trimester.
Clinical presentation
In adults, it is one of the most important causes of primary amenorrhea and accounts for approximately one-third of such cases.
Pathology
Genetics
Turner syndrome is classically characterized by the absence of one X chromosome copy (45 XO), with the missing chromosome most frequently (two-thirds) being the paternal one. Most cases occur as a sporadic event.
However, the classic genetic change is not present in all cases. Three main subtypes include:
complete monosomy (45XO): ~60%
even though it is relatively common, almost all 45 XO fetuses will spontaneously abort, with 70% lost between 16 weeks and term
partial monosomy (structurally-altered X chromosome): ~15%
mosaicism (XO and another sex karyotype): ~30%
Unlike the common trisomies, there is no association with maternal age.
Markers
serum alpha-fetoprotein (AFP): decreased
beta HCG
elevated if hydrops present
decreased if no hydrops
serum inhibin
elevated if hydrops present
absent if hydrops absent
Associations
hypertension
glucose intolerance
inflammatory bowel disease
hypothyroidism: due to the formation of thyroid antibodies (most commonly Hashimoto thyroiditis)
gonadal dysgenesis / ovarian dysgenesis
Complications
In utero complications include:
development of hydrops fetalis: usually from fluid overload secondary to lymphatic failure
Radiographic features
Antenatal ultrasound
cystic hygroma: may appear septated; one of the most typical features of Turner syndrome
increased nuchal thickness
increased nuchal translucency
coarctation of the aorta: 15-20%
bicuspid aortic valve
horseshoe kidney / pelvic kidney
mild IUGR
features related to complicating hydrops fetalis
short fetal limbs
Postpartum-to-adulthood features
Musculoskeletal
scoliosis
short 4th metacarpal: positive metacarpal sign
narrowing scapholunate angle: positive carpal sign
abnormal medial femoral condyle
decreased carpal angle: Madelung deformity
short stature
webbed neck
valgus deformity of the elbow: increased carrying angle (cubitus valgus)
Pelvic ultrasound
streaky uterus
streak ovary
Gastrointestinal
pyloric stenosis
Treatment and prognosis
Overall prognosis very variable is dependent on associated anomalies. While the vast majority of fetuses are aborted in the second trimester, some may have a long life expectancy. Cases with mosaicism do much better. Mental development is unaffected.
History and etymology
It is named after the American endocrinologist Henry H Turner (1892-1970) 7 who first described the syndrome in 1938.
Differential diagnosis
General differential considerations include:
Noonan syndrome: can have similar phenotypical features but normal karyotype
what syndrome is this.
What are the signs
incidence
risk factors
ddx x 1

Edwards syndrome
- 2nd most common trisomy
- 1:3000
- Increased incidence with increased maternal age
- Of the three trisomies, has the highest rate of major morphological abnormality
- CHD 90-95% (ASD, VSD, PDA)
- Choroid plexus cysts 40%
- Neural tube defects 20%
- IUGR early 60-90%
- single umbilical artery
- rocker bottom feet
- Cystic Hygroma 20%
- Horse shoe kidney in 20%
- Low MSAFP, estradiol, Bhcg
- clenched hands with an overlap of 2nd and 3rd digits: 80%
- bowel containing omphalocele
- Differential diagnosis
Pena-Shokeir syndrome (pseudotrisomy 18):
Dr Daniel J Bell◉ and Assoc Prof Frank Gaillard◉◈ et al.
Edwards syndrome, also known as trisomy 18, along with Down syndrome (trisomy 21) and Patau syndrome (trisomy 13), make up the only three autosomal trisomies to be compatible with extrauterine life in non-mosaic forms, albeit in the case of Edward syndrome only for a week or so.
Epidemiology
After Down syndrome, it is the second most common autosomal trisomy and the overall incidence is estimated to be at ~1:3000-8000. There is an increase in incidence with increasing maternal age.
Clinical presentation
Trisomy 18 fetuses can have multiple anomalies in multiple systems. Over 130 features have been reported. Out of the three main trisomies, this trisomy has the highest incidence of major structural anomalies. Features include:
congenital heart disease: 90-95%
atrial septal defect (ASD)
ventricular septal defect (VSD)
patent ductus arteriosus (PDA)
dextrocardia
central nervous system or spinal abnormalities: 70%
choroid plexus cysts (especially if cysts are large and bilateral 6): found in 25-43% with trisomy 18
agenesis of the corpus callosum: <10%
Dandy-Walker continuum
mega cisterna magna 6
intellectual disability
neural tube defects: ~20% 7
myelomeningocele
spina bifida
intrauterine growth restriction (IUGR): 60-90% (tends to occur from early in gestation)
facial/calvarial abnormalities
micrognathia
dolichocephaly: strawberry skull: as a result of frontal lobe hypoplasia
low set ears
hypertelorism
cleft lip +/- palate
cystic hygroma: ~20%
skeletal abnormalities hand anomalies
clenched hands with an overlap of 2nd and 3rd digits: 80%
radial ray anomalies
absent thumb
feet anomalies
rocker bottom feet: a typical feature
clubfeet
prominent occiput
short neck
11 pairs of ribs 10
umbilical cord
single umbilical artery: 80%
umbilical cord cysts
umbilical cord pseudocysts
gastrointestinal: thoracic anomalies
bowel containing omphalocele: 20-25%
congenital diaphragmatic hernia: ~10%
renal anomalies
antenatal hydronephrosis
urethral duplication
horseshoe kidney: 20% 3
Pathology
Markers
The following serological markers (often termed a triple screen) are generally lower than expected for that of pregnancy:
MSAFP: maternal serum alpha fetoprotein
estriol
beta human chorionic gonadotropin (bHCG)
Treatment and prognosis
The syndrome carries an extremely poor prognosis with a mean infant survival of 48 days 4. The risk of recurrence for a future pregnancy is ~1% greater than that adjusted for maternal age 7.
History and etymology
The syndrome was first described by John Hilton Edwards (1928–2007), a British medical geneticist 8. Historically it was also called E-trisomy or trisomy E 9,10.
Differential diagnosis
Pena-Shokeir syndrome (pseudotrisomy 18): an autosomal recessive condition that may share some overlap in its clinical features with trisomy 18


Radiologic Findings
The frontal chest radiograph (Fig. 46A1) shows a moderately enlarged heart with an egg-on-side configuration and increased pulmonary vascularity. The superior mediastinum is narrow because of thymic hypoplasia. Note that the anterior upper mediastinum is empty in lateral view (Fig. 46A2).
Figure 46B Schematic diagram of four types of truncus arteriosus as described by Collet and Edwards.
Diagnosis
Truncus arteriosus with DiGeorge syndrome
Differential Diagnosis
Egg-on-side appearance:
Complete transposition of the great arteries: pulmonary vascularity, variable
Pulmonary atresia with intact ventricular septum: diminished pulmonary vascularity
Truncus arteriosus: increased pulmonary vascularity
Boot-shaped heart: In truncus arteriosis the heart may also be boot shaped, but this is less common.
Tetralogy of Fallot: normal heart size and diminished pulmonary vascularity
Pulmonary atresia with ventricular septal defect: normal heart size with diminished pulmonary vascularity or enlarged heart with increased pulmonary vascularity
Truncus arteriosus: moderate cardiomegaly with increased pulmonary vascularity
Narrow superior mediastinum:
Complete transposition of the great arteries with postnatal regression of the thymus
Truncus arteriosus with thymic hypoplasia in association with DiGeorge syndrome or postnatal regression of the thymus
Discussion
Clinical Findings
Most patients with truncus are recognized as having congenital heart disease during the neonatal period. During the first few weeks of life, persistence of increased pulmonary vascular resistance results in mild cyanosis with little evidence of heart failure. As the pulmonary vascular resistance decreases, cyanosis may disappear and be replaced by signs of congestive heart failure. When the truncal valve is severely regurgitant, the signs of congestive heart failure may manifest immediately after birth. Generally, the heart is overactive, and a pansystolic murmur is heard at the left precordium. Microdeletion of chromosome 22q11 is seen in ~40% of patients with truncus, and patients with this deletion include DiGeorge and velocardiofacial syndrome cases.
What syndrome is this finding associated with

http://www.ajnr.org/content/35/11/2186
Di George
CATCH22
C - cavum septum pelucidum, cleft palate,
A - Abnormal Facies (hypertelorism, low set ears, short philtrum, among others)
T - Trunchus ateriosus, Thymic Hypoplasia
C - cardiac anomalies
H - hearing problems. Middle ear malformations. Hypoparathyroidism
22 - Microdeletion of 22q11.2


The Cri du Chat Syndrome
A. Everette James, Jr., Leonard Atkins22, Murray Feingold33, Murray L. Janower44
Author Affiliations
Published Online:Jan 1 1969https://doi.org/10.1148/92.1.50
Sections
Tools
Share
Abstract
SINCE THE discovery, in 1956, of the normal human chromosome number, four clinical syndromes associated with autosomal anomalies have been described. Lejeune, in 1963 (8), first recognized the cri du chat or “cat’s cry” syndrome which is the most recently appreciated of the four autosomal syndromes and the subject of this paper. Although over 60 cases of this syndrome have been recorded, only one description could be found in the radiologic literature (7).
Karyotype
The karyotype in children with the cri du chat syndrome contains the normal number of 46 chromosomes, but one of the members of the B group (Denver 4–55) has a deletion of much of the short arms (1) (Fig. 1). On the basis of autoradiographic studies of synthesis patterns of deoxyribonucleic acid and analysis of the long and short arm length, it is thought that the deletion involves number 5 chromosome in the majority of cases (15). Those with a deletion involving the short arms of number 4 chromosome are clinically indistinguishable from the usual case.
Clinical Features
Characteristic clinical features of the cri du chat syndrome are growth and mental retardation, muscle hypotonia, micrognathia and retrognathia, low-set ears, moon facies, oblique palpebral fissures with anti-mongoloid slants, and hypertelorism (Fig. 2), associated with a strange high-pitched plaintive cry reminiscent of the mewing of a distressed kitten (2,4–6,8–10). This “cat’s cry” is considered by most pediatricians to be diagnostic and is probably due to the immature larynx and epiglottis present in these children (13). Although the character of the cry changes as the child matures, it remains distinctly abnormal (12). Sound spectrograms will continue to show a high fundamental tone (14). The cry is so characteristic that physicians familiar with this syndrome have made the correct diagnosis from sound recordings without ever having seen the patient.
Radiographic Findings
Radiographic features in our 6 cases of this syndrome are microcephaly, low craniofacial vault ratio (Fig. 3), hypertelorism (Fig. 4), and faulty long-bone development secondary to muscle hypotonia. The most characteristic abnormalities are found on the skull radiograph. This microcephaly, low craniofacial vault ratio, and hypertelorism must be differentiated from the skull findings in trisomy 13–15 (11), trisomy 18 (3), and Pierre-Robin syndrome. Occasionally abnormalities are noted on the pelvic radiographs in which the acetabular angle is normal, but the iliac angle is increased. Other abnormalities that have been encountered are agenesis of the corpus callosum, horseshoe kidney, and congenital heart disease. These findings are not consistent, and our experience is too limited to consider them characteristic.
The radiographic features of the cri du chat syndrome are not as specific as those found in trisomy 13–15, trisomy 18, and mongolism (trisomy 21–22), and one must depend greatly upon clinical findings.
Lack of Myelination in the Anterior Limbs of the Internal Capsule Associated with Cri-du-Chat Syndrome: Case Report
H. Lee, S. You, +1 author Hyun-Hae Cho
Published 2015
Medicine
Investigative Magnetic Resonance Imaging
A 21-month-old girl with cri-du-chat syndrome in conjunction with developmental delay underwent brain magnetic resonance imaging (MRI). The MRI showed hypoplasia of the brain stem, a normal cerebellum, thinning of the corpus callosum, and a lack of myelination in both anterior limbs of the internal capsule. She also had neonatal bilateral subependymal cysts. We believe that the symmetrical lack of myelination in both anterior limbs of the internal capsule could be a diagnostic clue of cri-du-chat syndrome. LESS
View PDF
NF 1
MNEMONIC
CAFE SPOT
- Cafe au lait spots >6 in one year
- Axillary freckles
- Fibromas (neurofibromas 2 or plexiform 1)
- Eye hematomas - lisch nodules
- Sphenoid wing dysplaisa
- Positive family hx (Autosomal dominant)
- Optic nerve gliomas/Tumours
NF 2 Mnemonic
Mnemonics
MISME
M: multiple
I: inherited
S: schwannomas
M: meningiomas and
E: ependymomas
In fact, labeling this disorder neurofibromatosis type 2 is a misnomer, because neurofibromas are not a part of its constellation of abnormalities 1.
Rule of 2s
neurofibromatosis type 2
chromosome 22 (22q12) gene location
bilateral vestibular schwannomas
presents in 2nd-4th decades (around 20 years)
initial prevalence estimated to be 1:200,000, now thought ~1:25,000
what syndrome is this. What are the 3 main features of the syndrome. What is the risk of x cancer.

Birt-Hogg-Dubé syndrome
Dr Patrick Rock◉ and Dr Maxime St-Amant◉ et al.
Birt-Hogg-Dubé syndrome or folliculin gene-associated syndrome is a genetic multisystemic disease mainly characterised by:
multiple lung cysts and secondary spontaneous pneumothoraces
multiple bilateral renal tumours (particularly chromophobe renal cell cancer and oncocytoma)
cutaneous manifestations (angiofibromas, perifollicular fibromas, acrochordons, fibrofolliculomas, etc.)
On this page:
Article:
Epidemiology
Pathology
Radiographic features
History and etymology
Differential diagnosis
See also
References
Images:
Cases and figures
Epidemiology
Birt-Hogg-Dubé syndrome carries an estimated 25% risk of renal cell carcinoma 12.
Pathology
Genetics
Deletion mutation in the folliculin (FLCN) gene (short arm of chromosome 17), with autosomal dominant inheritance.
Radiographic features
CT
Lung cysts in Birt-Hogg-Dubé syndrome are usually multiple and have a lower zone predominance 11. Cyst morphology tends to be variable within each patient, with cysts commonly oval or lentiform and septated when large 4. The presence of paramediastinal cysts when disproportionate in number or oval (floppy) in shape is another distinguishing characteristic 11.
History and etymology
It is named after A R Birt, G R Hogg and W J Dubé who published their findings in 1978 7.
Differential diagnosis
Consider other cystic lung conditions such as:
lymphangioleiomyomatosis
cysts typically round, with diffuse (rather than lower zone) distribution
Langerhans cell histiocytosis
cysts variable in shape but classically co-existing with cavitating nodules. There is upper and mid zone predominance in size and number of cysts with sparing of costophrenic angles in contrast to lower lobe predominance in Birt Hogg Dube syndrome.
lymphocytic interstitial pneumonitis
co-existing ground-glass opacity and other parenchymal change
desquamative interstitial pneumonia
co-existing ground-glass opacity and other parenchymal change
See also
hereditary renal cancer syndromes
https://radiopaedia.org/cases/26269/studies/26395?lang=gb&referrer=%2Farticles%2Fbirt-hogg-dube-syndrome-5%3Flang%3Dgb%23image_list_item_5269718
Currarino Syndrome
- Memory aid: rino eating curry running up bottom
- Congenital abnormalities of the
- anorectum
- sacrum
- presacral soft tissues
- AKA
- Currarino Triado
- ASP triad
- anorectal malformation or congenital anorectal stenosis
- sacrococcygeal osseous defect (ALWAYS PRESENT)
- classically a hemisacrum
- sickle shaped sacrum
- Presacral mass
- anterior sacral meningocele
- tumour (mature teratoma)
- Dermoid/epidermoid cyst (rare)

GOLDENHAR SYNDROME
- Oculo-auriculo-vertebral dysplasia
Klippel-Feli Syndrome
Sturge Weber Syndrome


Sturge Weber

Sturge-Weber syndrome, or encephalotrigeminal angiomatosis, is a phakomatosis characterised by facial port wine stains and pial angiomas.
Approximately a third of patients have choroidal or scleral angiomatous involvement, which may be complicated with retinal detachment, buphthalmos or glaucoma 1.
Sturge-Weber syndrome is a rare syndrome, with an incidence estimated at 1 case in 20,000-50,000 persons 11.

Dyke-Davidoff-Masson syndrome is a condition characterised by hemicerebral atrophy/hypoplasia secondary to brain insult usually in fetal or early childhood period and is accompanied by ipsilateral compensatory osseous hypertrophy and contralateral hemiparesis.
It is characterised by:
thickening of the skull vault (compensatory)
enlargement of the frontal sinus (also ethmoidal and mastoid air-cells)
elevation of the petrous ridge
ipsilateral falcine displacement
capillary malformations (are a novel finding for children with Dyke-Davidoff-Masson syndrome) 6
In some sources, it is equated to hemispheric infarction, whereas in other sources any cause of cerebral hemiatrophy is included.
Some authors divide the condition into two types mainly dependant on clinical presentation age 12
infantile (congenital):
results from various aetiologies such as infection, neonatal or gestational vascular occlusion involving the middle cerebral artery, unilateral cerebral arterial circulation anomalies, and coarctation of the mid aortic arch.
patient becomes symptomatic in the perinatal period or infancy.
acquired
main causes of acquired type are trauma, tumour, infection, ischaemia, haemorrhage, and prolonged febrile seizures

Tuberous Sclerosis Radial bands in white matter

Lesch-Nyhan syndrome
- Lesch-Nyhan syndrome
- inherited as an X-linked recessive genetic disorde
- most often affects males.
- Symptoms
- impaired kidney function,
- acute gouty arthritis
- self-mutilating behaviors
- lip and finger biting
- head banging.


Rosai-Dorfman disease
Large amount of contiguous well defined enhancing tissue in the paranasal sinuses, nasal cavity and adjacent to the greater wing of sphenoids.
Similar para-sagittal mass close to the vertex.
Case Discussion
Rosai-Dorfman disease (RDD) (also known as sinus histiocytosis with massive lymphadenopathy (SHML)) is a rare benign idiopathic proliferative disease that involve phagocytic histiocytes.
Patient with histologically proven Rosai-Dorfman Disease.
Microscopic appearance
Histologically, it is characterised by an attenuated infiltration of lymphoplasmacytic cells and histiocytes of varying sizes. The large, pale histiocytic cells contain what looks like engulfed lymphocytes (“emperipolesis”) within their cellular borders.
https://radiopaedia.org/cases/rosai-dorfman-disease-2
































































